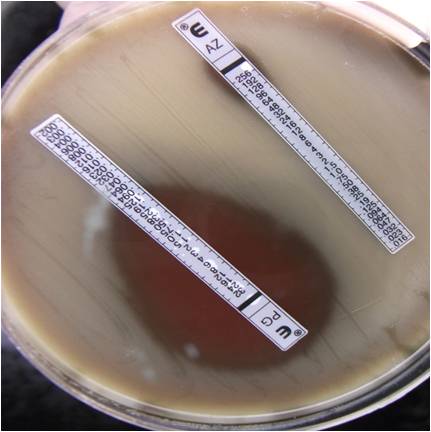

Chronic suppurative lung disease (CSLD, including bronchiectasis), acute lower respiratory infection (ALRI) and otitis media (OM) are major health problems affecting young Aboriginal and Torres Strait Islander children in the Northern Territory. However, the microbial processes underlying the development and progression of these diseases are poorly understood. The studies described in the above tabs aim to improve understanding of these processes, leading to better treatment and intervention strategies.
Aims:
- To improve understanding of polymicrobial ear and lung infections in Indigenous children. Our multidisciplinary approach includes generation of biomedical outcomes for clinical trials (antibiotics, vaccines, hygiene interventions), researching interactions with the host (immunity and nutritional deficiencies), pathogenesis and population biology, and polymicrobial bacterial community analyses:
- Microbiology and molecular service providing laboratory analyses for ear and respiratory studies
- Ear and respiratory microbiology/virology
- Population biology and polymicrobial bacterial community analyses
- Host responses
- To work closely with clinicians to ensure our biomedical research is performed in ways that may be best translated to health outcomes.
- Associate Professor Heidi Smith-Vaughan - Head of Child Health Laboratory Research and NHMRC Career Development Fellow
Primary project: Molecular public health in Australian Indigenous communities and developing countries in our region to improve ear and respiratory outcomes
- Dr Robyn Marsh - Frank Fenner Early Career Fellow
Primary project: Characterisation of bacteria and viruses associated with chronic suppurative lung disease in Indigenous children
- Jemima Beissbarth - Child Health Laboratory manager
Primary projects: Microbiology and molecular service, data management and CQI
- Dr Kim Hare - Senior research officer
Primary projects: Microbiology of bronchiectasis in Australian Indigenous children; Microbiology service, pneumococcal serotyping
- Dr Susan Pizzutto - NHMRC Early Career Fellow
Primary project: The immunologic mechanisms contributing to persistent lung inflammation and the pathogenesis of bronchiectasis in Northern Territory Indigenous children.
Primary project: Novel approaches for prevention of respiratory infections in Indigenous infants
- Jana Lai - PhD student
Primary project: Introducing pneumococcal vaccines to Vietnam
- Barbara MacHunter - Project manager
Primary project: MINOPOLI – microbes In the nasopharnx prior to lung infection
- Donna Woltring - Microbiologist
Primary project: Microbiology and molecular service
- Erin Price - Postdoctoral researcher
Primary project: Haemophilus genomics. Other projects include: bacterial evolution within the human host; Burkholderia pseudomallei infections in cystic fibrosis; genomics; transcriptomics; and bioinformatics
Microbiology and molecular service
Microbiology service:
- Microbiology service for surveillance and clinical trials (national and international)
- Culture and identification of bacteria associated with otitis media, skin, and lower respiratory infections
- Antimicrobial resistance testing
- Pneumococcal serotyping.
Molecular service:
- Quantitative PCR for respiratory bacteria
- Molecular typing of respiratory pathogens.
Image: Susceptibility testing of Streptococcus pneumoniae to the antibiotics azithromycin and penicillin.
CQI and consensus methods:
- Continuous quality improvement (CQI). We work to GCP and GCLP guidelines. Method development and comparisons are undertaken with institutions conducting similar analyses.
Current projects:
- MARS - Monitoring antimicrobial resistance and serotypes
- BRONCHOSCOPY - Bacteriology of the upper and lower airways of Indigenous children with bronchiectasis
- PREVIX and BOOST - Evaluating pneumococcal conjugate vaccines in Indigenous infants
- ABIS2 - Azithromycin to reduce morbidity of severe bronchiolitis in young children
- S4OMinCh – Surgery for otitis media in children
- BEST – Antibiotics for bronchiectasis exacerbations
- CHIRRP – Vaccination for CSLD exacerbations
- PBB – Protracted bacterial bronchitis: outcomes and predictors of recurrence
- PIPPA – Immune response to pneumococcal vaccination in adults
- AAAOM – Azithromycin vs placebo for acute otitis media.
Microbiology/virology
Molecular public health in Australian Indigenous communities and developing countries in our region to improve ear and respiratory outcomes
Dr Heidi Smith-Vaughan’s National Health and Medical Research Council (NHMRC) Career Development Fellowship aims to:
- Advance the knowledge and improve the understanding of the microbiological epidemiology and pathogenesis of ear and respiratory infections that can inform future interventions
- Value-add to clinical intervention trials through leading the laboratory analyses of specimens from various randomised controlled trials (antibiotics and vaccines)
- Capacity build the next generation of scientists.
Microbiology of bronchiectasis in Australian Indigenous children
Kim Hare’s PhD aims to use microbiological findings to improve the clinical management of children with bronchiectasis. The specific aims of this project are to:
- Describe the bacteriology of the upper and lower airways of Australian Indigenous children with bronchiectasis
- Describe the impact of antibiotic treatment on resistance of bacterial respiratory pathogens in the upper and lower airways of Australian Indigenous children with bronchiectasis.
Introducing pneumococcal vaccines to Vietnam
Jana Lai’s PhD focuses on the epidemiology of pneumococcal and H. influenzae carriage and disease in a Vietnamese population on the verge of pneumococcal conjugate vaccine introduction. Her PhD studies include:
- Central Australia serotype 1 carriage study during an invasive disease outbreak
- Pneumococcal and H. influenzae specimen transport studies – in vitro and ex vivo
- Burden of chest X-ray confirmed pneumonia in Vietnamese children, 2010-2012
- Carriage of respiratory pathogens in Vietnamese children at 2 months of age.
Jana is primarily based at the Pasteur Institute in Ho Chi Minh City.
MINOPOLI (Microbes In the NasOpharynx Prior tO Lung Infection) study
The aims of this study are to:
- Define the contribution of viral infection and increased nasopharyngeal bacterial load to episodes of acute lower respiratory infection in Indigenous children
- Explore the incidence of respiratory human papilloma virus in infants and determine its relationship to acute lower respiratory infection.
Population biology and polymicrobial bacterial community analyses
Characterisation of the polymicrobial microecology of chronic respiratory infections in Indigenous children:
Dr Robyn Marsh’s fellowship aims to improve respiratory health for Indigenous children through better understanding of infectious disease pathogenesis. Her specific interests are in the microbial dynamics of chronic respiratory infections. Her research draws together bacterial, viral and biofilm studies to achieve better understanding of the upper and lower airway microbiomes in paediatric patients with chronic suppurative lung disease and otitis media.
Quantification of respiratory pathogens in the upper and lower airways of Indigenous children with bronchiectasis:
Honours student Jasmin Webb is exploring the relative abundance of respiratory bacteria in the upper and lower airways of children with chronic suppurative lung disease.
The specific aims of this project are to:
- Compare the bacterial load and relative abundance of Haemophilus influenzae in upper and lower airway specimens from i) children with bronchiectasis and ii) control children who do not have bronchiectasis
- Determine if Pseudomonas aeruginosa is present in the upper or lower airways of children with bronchiectasis.
Nontypeable Haemophilus influenzae (NTHi) genomics:
The aim of this study is to identify NTHi gene or gene variant signatures associated with disease by comparing the genomic content of disease- and carriage-associated NTHi and related commensal Haemophilus species.
Bioinformatics by Erin Price and Derek Sarovich. These data may inform clinically relevant identification of NTHi, and studies of NTHi pathogenesis and vaccine research.
Otitis media projects:
- Culture-independent analysis of the bacteriology associated with acute otitis media in Indigenous Australian children
- Watch this space. Funding pending for CSOM microbiomics, and adenoid and middle ear fluid biofilm studies.
Immunity to non-typeable Haemophilus influenzae in Northern Territory children with chronic suppurative lung disease:
Susan Pizzutto’s research aims to understand the role of the child’s immune system in the development of chronic respiratory illness.
- Lower airway inflammatory processes in children with chronic suppurative lung disease (CSLD)
- H. influenzae-specific immunity in children with CSLD
- The effect of Synflorix on H. influenzae-specific immune response in children with CSLD.
Novel approaches for prevention of respiratory infections in Indigenous infants:
Michael Binks’ research is looking at:
- Maternal 23-valent pneumococcal polysaccharide vaccination and respiratory outcomes for infants (Pneumum study)
- Maternal and infant vitamin D levels and vaccine immune responses
- Infant vitamin D levels and risk of acute lower respiratory infection.

Cytoslides of bronchoalveolar lavage showing airway eosinophilia (E) with neutrophilia